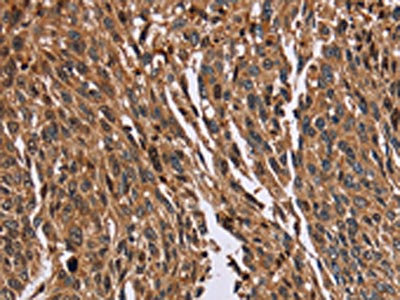

HMGN5 Antibody
-
中文名稱:HMGN5兔多克隆抗體
-
貨號:CSB-PA921993
-
規格:¥1100
-
圖片:
-
The image on the left is immunohistochemistry of paraffin-embedded Human prostate cancer tissue using CSB-PA921993(HMGN5 Antibody) at dilution 1/20, on the right is treated with fusion protein. (Original magnification: ×200)
-
The image on the left is immunohistochemistry of paraffin-embedded Human lung cancer tissue using CSB-PA921993(HMGN5 Antibody) at dilution 1/20, on the right is treated with fusion protein. (Original magnification: ×200)
-
Gel: 8%SDS-PAGE, Lysate: 40 μg, Lane: 231 cells, Primary antibody: CSB-PA921993(HMGN5 Antibody) at dilution 1/100, Secondary antibody: Goat anti rabbit IgG at 1/8000 dilution, Exposure time: 5 minutes
-
-
其他:
產品詳情
-
Uniprot No.:
-
基因名:HMGN5
-
別名:High mobility group nucleosome binding domain 5 antibody; High mobility group nucleosome-binding domain-containing protein 5 antibody; Hmgn5 antibody; HMGN5_HUMAN antibody; NBP 45 antibody; NSBP 1 antibody; NSBP1 antibody; Nucleosomal binding protein 1 antibody; Nucleosome binding protein 1 antibody; Nucleosome-binding protein 1 antibody
-
宿主:Rabbit
-
反應種屬:Human
-
免疫原:Fusion protein of Human HMGN5
-
免疫原種屬:Homo sapiens (Human)
-
標記方式:Non-conjugated
-
抗體亞型:IgG
-
純化方式:Antigen affinity purification
-
濃度:It differs from different batches. Please contact us to confirm it.
-
保存緩沖液:-20°C, pH7.4 PBS, 0.05% NaN3, 40% Glycerol
-
產品提供形式:Liquid
-
應用范圍:ELISA,WB,IHC
-
推薦稀釋比:
Application Recommended Dilution ELISA 1:1000-1:2000 WB 1:200-1:1000 IHC 1:50-1:200 -
Protocols:
-
儲存條件:Upon receipt, store at -20°C or -80°C. Avoid repeated freeze.
-
貨期:Basically, we can dispatch the products out in 1-3 working days after receiving your orders. Delivery time maybe differs from different purchasing way or location, please kindly consult your local distributors for specific delivery time.
-
用途:For Research Use Only. Not for use in diagnostic or therapeutic procedures.
相關產品
靶點詳情
-
功能:Preferentially binds to euchromatin and modulates cellular transcription by counteracting linker histone-mediated chromatin compaction.
-
基因功能參考文獻:
- Findings suggest that a miR-140-5p/HMGN5/autophagy regulatory loop plays a critical role in chemoresistance in osteosarcoma. In conclusion, our data elucidated that miR-140-5p promoted autophagy mediated by HMGN5 and sensitized osteosarcoma cells to chemotherapy. PMID: 28341864
- High HMGN5 expression is associated with osteosarcoma invasion. PMID: 28627703
- We observed decreased miR-409-3p expression in glioma, and overexpression of miR-409-3p repressed glioma cell invasion and proliferation by targeting HMGN5, an oncogene associated with glioma PMID: 28109076
- HMGN5 regulated the expression of multidrug resistance 1, cyclin B1, and Bcl-2. PMID: 28914995
- NSBP1 was highly expressed in NSCLC cells. NSBP1 siRNA knockdown suppressed NSCLC cell proliferation and invasion. miR326 has a putative binding site in the NSBP1 3'UTR. NSBP1 overexpression abolished miR326 inhibition of cyclin B1 and MMP9 expression. PMID: 26548724
- HMGN5 overexpression is correlated with advanced pathological grade and poorer prognosis in meningiomas PMID: 26315299
- Decreased miR-340 expression may contribute to the development and progression of prostate cancer through a mechanism that involves HMGN5. PMID: 26394192
- Our data first time identified miR-186 as the upstream regulator of NSBP1 PMID: 26290438
- High HMGN5 expression is associated with urothelial bladder cancer. PMID: 25796505
- HMGN5 is an oncogene and plays an important role in prostate cancer tumorigenesis and progression. the level of HMGN5 may be used as a biomarker to predict the patients that would benefit from gemcitabine treatment. PMID: 25572120
- HMGN5 plays an oncogenic role in human breast cancer by inhibiting cell proliferation and invasion, and activating apoptosis, which could be exploited as a target for therapy in human breast cancer. PMID: 25315189
- HMGN5 knockdown sensitizes prostate cancer cells to ionizing radiation PMID: 25307178
- HMGN5 plays oncogenic role in osteosarcoma by promoting cell proliferation and invasion, and could be exploited as a target for therapy in osteosarcoma. PMID: 24687550
- HMGN5 is a critical factor in the development of chemoresistance through regulating autophagy, and it offers a novel target for improving osteosarcoma therapy. PMID: 24664583
- Data indicate that cells lacking either high mobility group protein N5 (HMGN5) and lamina-associated polypeptide 2alpha (LAP2alpha) showed that loss of either protein affects the genome-wide distribution of the remaining partner. PMID: 23673662
- HMGN5 silencing to significantly inhibit A549 and H1299 cell proliferation. PMID: 22994738
- HMGN5 may be a potential molecular target with therapeutic relevance for the treatment of prostate cancer. PMID: 22504871
- NSBP1 plays oncogenic role in clear cell renal cell carcinoma (ccRCC) by promoting cell proliferation and invasion. PMID: 22420896
- The data of study suggested that HMGN5 may play a critical role in the development of gliomas. PMID: 21373965
- these results suggest that NSBP1 promotes the viability of bladder cancer cells through increased cell proliferation PMID: 21695596
- HMGN5 has a highly disordered structure, binds dynamically to nucleosome core particles, modulates the binding of H1 to chromatin, reduces the compaction of the chromatin fiber, and affects transcription. PMID: 21518955
- A positive correlation was observed between NSBP1 expression and cell proliferation and apoptosis in DU145 cells. PMID: 20531280
- The structure of the HMGN5 gene and the known properties of the HMGN5 protein, are described. PMID: 20123071
顯示更多
收起更多
-
亞細胞定位:Nucleus.
-
蛋白家族:HMGN family
-
組織特異性:Ubiquitously expressed.
-
數據庫鏈接:
Most popular with customers
-
-
YWHAB Recombinant Monoclonal Antibody
Applications: ELISA, WB, IHC, IF, FC
Species Reactivity: Human, Mouse, Rat
-
Phospho-YAP1 (S127) Recombinant Monoclonal Antibody
Applications: ELISA, WB, IHC
Species Reactivity: Human
-
-
-
-
-